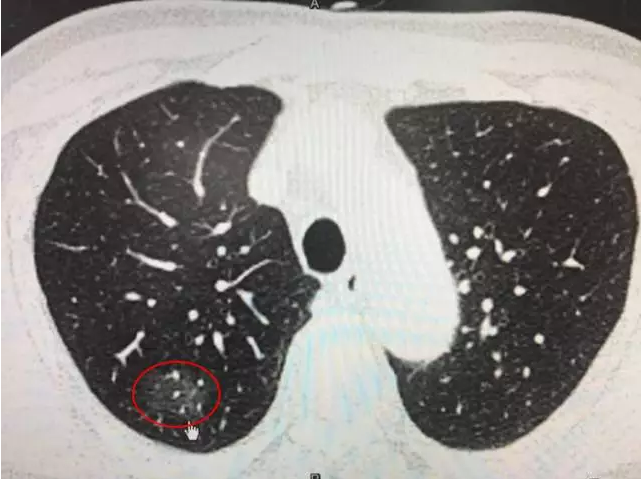
肺磨玻璃结节(GGO)(转发) - 好大夫在线

肺磨玻璃密度结节处理,牢记这六点足矣!
293x220 - 9KB - JPEG

肺磨玻璃密度结节处理,牢记这六点足矣!
300x220 - 7KB - JPEG

肺磨玻璃影的治疗
512x512 - 30KB - JPEG

肺磨玻璃结节之3---磨中有实必恶性? - 好大夫
1000x666 - 67KB - JPEG

肺磨玻璃结节之2---AAH到AIS的演变 - 好大夫在
1279x1706 - 158KB - JPEG
遇到肺磨玻璃结节莫惊慌(2017.1版)\/谢冬大夫点
713x465 - 37KB - JPEG

肺磨玻璃结节之2---AAH到AIS的演变 - 好大夫在
797x649 - 31KB - JPEG

肺磨玻璃结节的生长速度如何,会不会突然变成
696x478 - 48KB - JPEG
肺磨玻璃结节(GGO)(转发) - 好大夫在线
641x479 - 302KB - PNG

肺磨玻璃结节的生长速度如何,会不会突然变成
615x416 - 28KB - JPEG

肺磨玻璃结节是肺癌吗--遇到肺磨玻璃结节莫惊
924x558 - 62KB - JPEG

肺磨玻璃影的治疗
600x337 - 32KB - JPEG
遇到肺磨玻璃结节莫惊慌(2017.1版)\/谢冬大夫点
640x445 - 29KB - JPEG

肺磨玻璃结节之2---AAH到AIS的演变 - 好大夫在
587x585 - 33KB - JPEG

2013Fleischner学会肺磨玻璃密度结节处理指南
1152x864 - 39KB - PNG
双侧胸廓饱满,双肺血气管纹理增多,右肺上叶见一不规则磨玻璃密度结节,根据你的描述这种情况主要考虑是
1.左肺下叶不规则结节 2.右肺上叶后段磨玻璃密度结节,考虑恶性病变可能性大。3.右肺上叶后段实性结节影,
肺部磨玻璃结节到底要不要紧 它与肺癌究竟有何关系 龙华医院胸外科寿伟臻主任医师 向大家肺磨玻璃结节的
检查所见:双侧胸廓饱满,双肺血气管纹理增多,右肺上叶见一不规则磨玻璃密度结节,大小约2.4cm×1.8cm,
胸廊对称,左上肺磨玻璃病灶,形态不规则,边缘尚清,其规格16.6X11.4mm,其内密度欠均匀,局部胸膜粘连,
通常发现肺内的孤立磨玻璃结节,需要结合病人是否高危人群,比如有无 肺癌 家族史、有无吸烟史形态不规则,
肺部右上叶毛玻璃节结患病多久:半年内 2015年春节期间患支气管炎,5月患2016.7.14做CT检查发现右肺上叶前
健康咨询描述:做支气管镜检查正常病情分析: 这种情况一般考虑是需要到医院进一步检查一下比较好,建议在
肺部疾病检查,上海市肺科医院胸外科 谢冬一、肺磨玻璃结节是神马东东?肺磨玻璃结节英文叫GGO(GGN),指